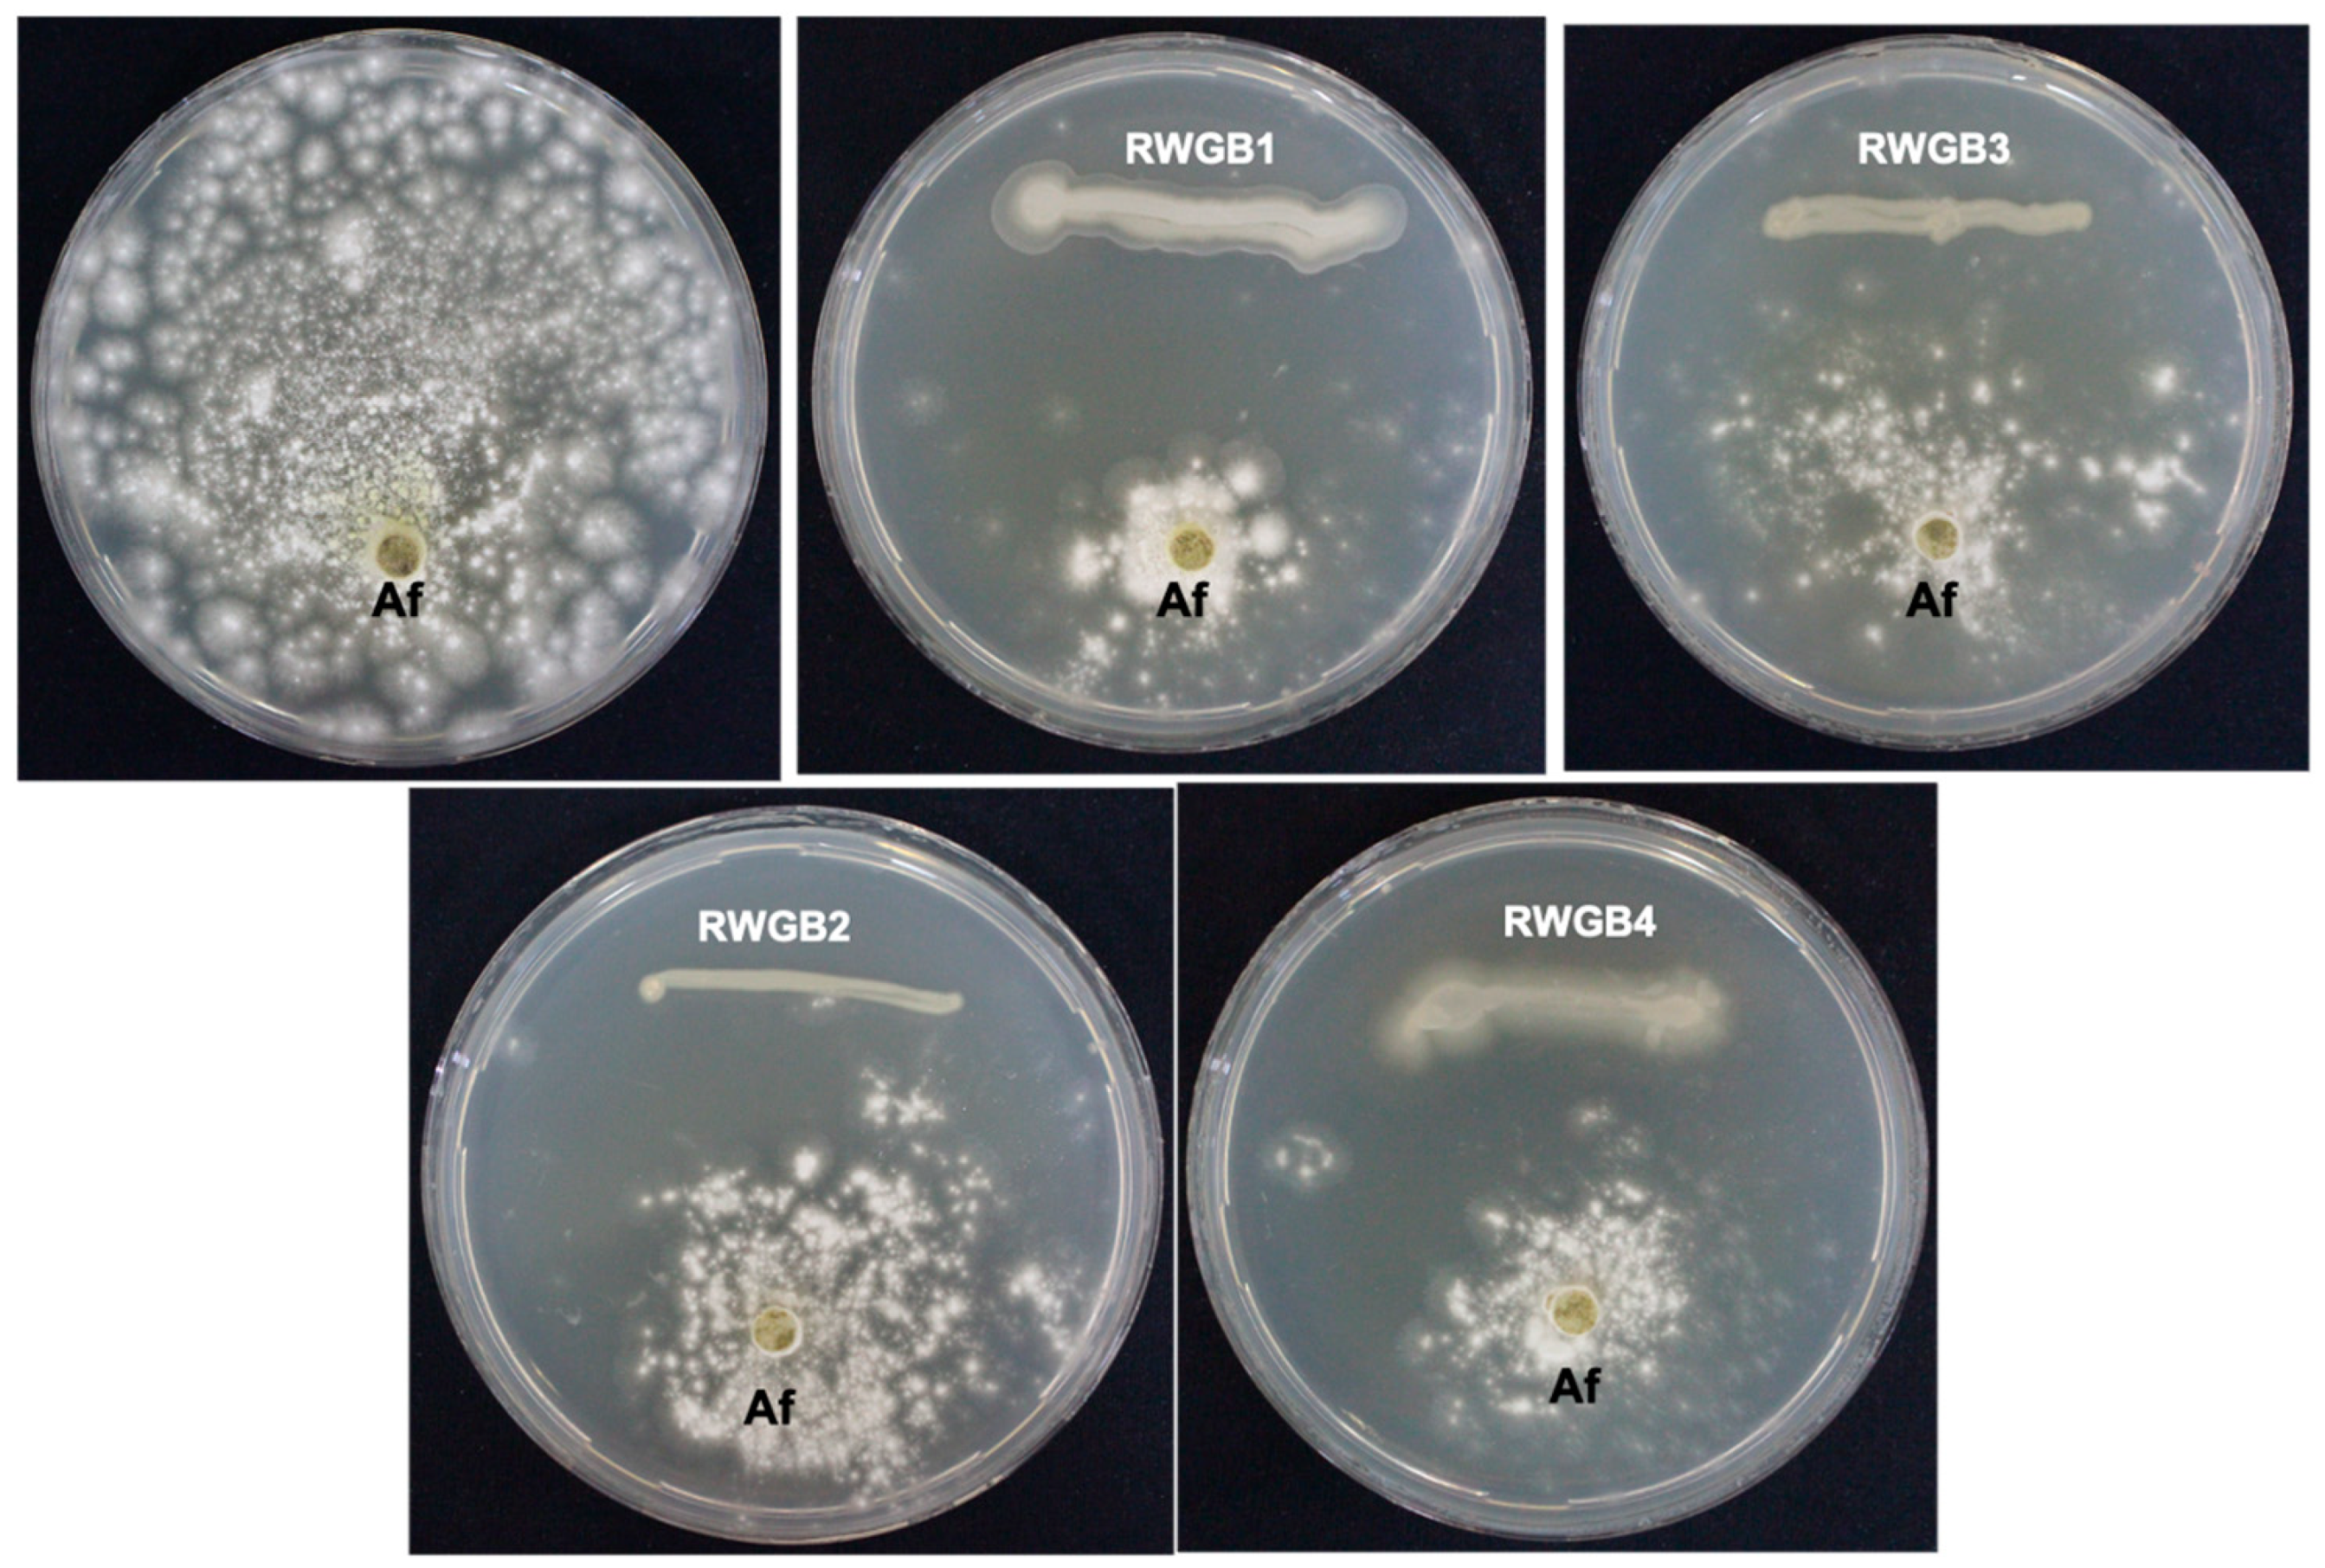
Jof 10 00377 g001

1. Introduction
Aflatoxin contamination in foods, as well as in livestock and poultry feeds, is a major global concern due to its carcinogenic and immunosuppressive properties [
1,
2]. The ingestion of an aflatoxin-contaminated diet can lead to acute and chronic aflatoxicosis in both humans and animals. Chronic aflatoxicosis can result in hepatocellular carcinoma, cirrhosis, and impaired immunity. Acute aflatoxicosis is characterized by symptoms like high fever, vomiting, liver failure, ascites, edema of feet, and jaundice. Prolonged exposure to aflatoxins may increase the risk of liver, lung, kidney, or colon cancers in both humans and animals [
3]. Furthermore, pulmonary aspergillosis has been reported to aggravate the severity of coronavirus disease in immunocompromised individuals [
4]. Twenty-eight fungal species belonging to
Aspergillus sections
Flavi (22 species),
Nidulantes (4 species), and
Ochraceorosei (2 species) have been identified as aflatoxin producers [
5]. The primary producers of aflatoxins are
Aspergillus flavus,
A. parasiticus, and
A. nomius [
5,
6]. Aflatoxin is produced and stored in specialized vesicles called “aflatoxisomes” within toxigenic cells of
Aspergillus spp. before being exported by exocytosis [
7]. A wide variety of agricultural commodities, including corn, peanut, sorghum, rice, pearl millet, soybean, sunflower, cotton, chili, black pepper, pistachio, almond, Brazil nut, walnut, and coconut are commonly contaminated with aflatoxins [
8].
Aflatoxins are chemically classified as difurocoumarin derivatives, consisting of a bifuran ring fused to a coumarin nucleus, with a pentenone ring in B-type aflatoxins or a lactone ring in G-type aflatoxins. Currently, more than 20 types of aflatoxins have been identified [
9]. Among them, aflatoxin B1 (C
17H
12O
6; MW 312), B2 (C
17H
14O
6; MW 314), G1 (C
17H
12O
7; MW 328), and G2 (C
17H
14O
7; MW 330) are frequently found in food commodities [
3,
10]. Aflatoxin M1 (C
17H
12O
7; MW 328) and M2 (C
17H
14O
7; MW 330) are metabolites of aflatoxins B1 and B2, respectively, commonly found in the milk of lactating mammals fed with aflatoxin-contaminated feed [
6]. Aflatoxin B1 (AFB1; PubChem CID: 186907) is the most hazardous foodborne mycotoxin to humans and animals, classified by the International Agency for Research on Cancer as a Group1 carcinogen [
11].
Various detoxification methods have been used to mitigate aflatoxin contamination in foods and feeds, with the goal of minimizing their deleterious effects [
12]. Physical degradation methods encompass heat treatment, ultraviolet irradiation, Cobalt-60 gamma irradiation, photocatalysis, electron beam irradiation, and cold plasma treatment. Chemical degradation methods include ozonation, chlorine dioxide oxidation, and treatments with lactic acid, while biological degradation utilizes beneficial microorganisms and natural plant products [
13]. Of the various techniques, biological degradation methods are considered efficient and environmentally friendly [
14,
15,
16]. Biologically based approaches primarily focus on suppressing the growth of toxigenic
Aspergillus spp. and detoxifying aflatoxin-contaminated agricultural products [
17]. Several strains of lactic acid bacteria and yeast can bind to mycotoxins and reduce their bioavailability in foods or feeds [
14,
18,
19]. In addition, the microbial enzymes can transform mycotoxins, further reducing their toxicity before excretion [
20]. Different types of bacteria found in the intestinal tract of animals [
21,
22,
23], soil, and other environments [
24,
25,
26,
27] have been reported to detoxify mycotoxins. Insects, in particular, stored product insects, are commonly exposed to aflatoxins in their natural environment. These insects are known to possess detoxification mechanisms that enable the breakdown and elimination of toxins from their system [
28,
29]. The involvement of metabolic enzymes such as NADPH-dependent reductases and hydroxylases in the detoxification of aflatoxins in insects has been documented [
29]. Diverse microorganisms, including fungi, bacteria, protists, and archaea, have been found to live in insect guts [
30,
31]. Various factors, including gut anatomy, digestive enzymes, pH, and diet, influence the diversity of the gut microbiota [
30,
32]. The gut microbial communities play important roles in feeding, digestion, protection from pathogens and parasites, and resistance to pesticides [
31]. We hypothesized that the symbiotic bacteria living in the gut of insects may possess the capacity to bind/degrade AFB1 and reduce its toxic effects. The objectives of this study were to (i) isolate and characterize bacteria residing in the gut of the rice weevil (
Sitophilus oryzae L.) (Coleoptera: Curculionidae) collected from AFB1-contaminated corn kernels, (ii) assess in vitro antagonistic potential of bacterial isolates against
A. flavus, (iii) determine AFB1 degradation ability of the bacterial isolates and their culture supernatants, (iv) analyze the degradation products of AFB1 following treatment with the culture supernatants of the bacterial isolates, and (v) test the potential of the bacterial isolates to produce antifungal volatile organic compounds (VOCs) against
A. flavus.
4. Discussion
Decontamination of aflatoxins from food products presents a challenge due to their high stability under normal food processing conditions. Biological degradation of aflatoxins, using microorganisms or their byproducts, is considered an ideal method to reduce the toxic effects of aflatoxins due to their effectiveness and environmental friendliness [
13,
18,
44,
45]. In this study, four bacterial species, viz.,
B. subtilis RWGB1,
B. oceanisediminis RWGB2,
B. firmus RWGB3, and
P. aeruginosa RWGB4, residing in the gut of the rice weevil were isolated. These gut-inhabiting bacterial isolates exhibited direct antagonistic activity against
A. flavus, as evidenced by the production of inhibition zones in the in vitro co-culture assay. The antagonistic activity of
B. subtilis [
46],
B. oceanisediminis [
47],
B. firmus [
48], and
P. aeruginosa [
49], isolated from different sources, against a diverse range of fungi has been described. Several studies have reported that symbiotic bacteria associated with the gut of insects exhibit antagonistic activity against fungi [
50,
51,
52]. For example, Huang et al. [
50] demonstrated that
B. subtilis from the gut of
Blattella germanica retarded the growth of
Beauveria bassiana. Miller et al. [
53], while examining the antifungal activity of honey bee-associated bacteria, observed that the bacterial symbiont
Bombella apis could suppress the growth of
A. flavus and
Beauveria bassiana in vitro. Amer et al. [
51] showed that
Klebsiella pneumonia isolated from the
Periplaneta americana gut exhibited inhibitory activity against
A. flavus. Shehabeldine et al. [
52] found that cell-free culture supernatants of a few bacterial species, including
Pseudomonas aeruginosa obtained from the gut of
Apis mellifera displayed in vitro antifungal activity against
Aspergillus sp., the causal agent of Stonebrood disease of honey bee. The inhibitory activity of the rice weevil gut-associated bacterial isolates against
A. flavus in the dual culture assay in this study is likely due to their production of diffusible antifungal metabolites [
54] and depletion of essential nutrients in the media [
55]. The differences in
A. flavus growth inhibition could be attributed to differences in the concentration and toxicity of the metabolites produced by these bacterial isolates.
SEM analysis of
A. flavus hyphae sampled from the inhibition zone in a dual culture assay plate showed aberrant morphologies, including wrinkling of the surface, shrinkage, and distortion. Similar findings were reported by Al-Daghari et al. [
56] when
P. aphanidermatum, the damping-off pathogen of cucumber, was co-cultivated with antagonistic strains of
Serratia marcescens and
Pseudomonas spp. Likewise, shrinkage of
P. aphanidermatum mycelium was observed when the oomycete was co-cultured with an antagonistic fungus,
Aspergillus terreus [
57]. The shrinkage of fungal hyphae may be attributed to the loss of internal cell contents [
58].
Several microorganisms with the potential of degrading AFB1 have been isolated from various sources, including soil [
59,
60], fish gut [
61], and fermented foods [
19]. These microorganisms include
Saccharomyces cerevisiae [
62], lactic acid bacteria [
63,
64,
65],
B. subtilis [
19,
61,
66],
B. licheniformis [
17],
B. amyloliquefaciens [
67],
P. putida [
59], and
Streptomyces spp. [
68]. The bacterial isolates from the rice weevil gut in this study also demonstrated the ability to reduce AFB1 levels.
B. subtilis RWBG1 was highly efficient, removing 84.2% of AFB1.
B. oceanisediminis RWGB2,
B. firmus RWGB3, and
P. aeruginosa RWGB4 removed 66.5%, 63.6%, and 48.9% of AFB1, respectively. These results are consistent with the previous reports that indicated the degradation of AFB1 by various bacterial strains [
17,
19,
60,
61,
69,
70]. El-Nezami et al. [
69] reported that
Lactobacillus rhamnosus GG, a lactic acid bacterium, removed 80% of AFB1 from the toxin-amended culture medium. Gao et al. [
61] found that
B. subtilis from fish gut degraded 81.5% of AFB1. Rao et al. [
17] demonstrated that
B. licheniformis degraded over 90% of AFB1. Ali et al. [
60] reported that
P. fluorescens strain SZ1 isolated from soil degraded 100% of AFG1 and 99% of aflatoxin B1, B2, and G2. Al-Mamari et al. [
19] found that live cells of
B. subtilis YGT1 obtained from yogurt degraded 83.8% of AFB1 after 48 h of incubation at 30 °C. El-Nezami et al. [
71] showed that even heat- and acid-treated dead cells of
L. rhamnosus GG could bind AFB1. The peptidoglycan in the cell wall of
L. rhamnosus GG has been reported as crucial for binding AFB1 [
72].
The results of the present study also showed that the culture supernatant of
P. aeruginosa RWBG4 exhibited the highest AFB1-degrading capability (87.1%), followed by
B. firmus RWGB3 (43.5%) and
B. oceanisediminis RWGB2 (23.2%).
B. subtilis RWGB1 culture supernatant was the least effective, with 8.4% degradation. Xu et al. [
73] showed that
B. shackletonii L7 significantly reduced AFB1 levels (92.1%), with the culture supernatant degrading more AFB1 than live cells or cell extracts. Al-Mamari et al. [
19] reported that the culture supernatant of
B. subtilis YGT1 degraded 81.3% of AFB1 in culture medium after 48 h of incubation at 30 °C. The furofuran and lactone rings are the critical sites for the toxic effects of aflatoxins. Modifications to these ring structures typically lead to the loss of the toxic effects of aflatoxins [
74,
75]. Several bacteria and fungi have been reported to degrade aflatoxins by modifying the lactone ring or cyclopentanone ring structures [
17,
70,
72,
76]. The results of the present study suggest that
B. subtilis RWGB1 eliminates AFB1 primarily through physical binding, while
P. aeruginosa RWBG4,
B. firmus RWGB3, and
B. oceanisediminis RWGB2 degrade it through physical binding and by using their extracellular metabolites.
The degradation of AFB1 upon incubation with the bacterial culture supernatants was confirmed by LC/MS analysis. AFB1 degraded products
m/
z 206, 258, 284, and 287 were detected following treatment with the culture supernatants of the rice weevil gut bacteria, compared to AFB1-treated with uninoculated nutrient broth (control), confirming the degradation of AFB1. Several studies documented the molecular structures of AFB1 degradation products [
77,
78,
79,
80]. Cucullu et al. [
78] showed that ammoniation treatment resulted in the formation of dihydro-4-hydroxy-6-methoxyfuro [2,3-b] benzofuran (MW 206) from AFB1. Lee et al. [
77] documented the generation of a product with a molecular mass of 286 from AFB1 following treatment with NH
4OH. Wang et al. [
81] reported that live cells and the culture supernatant of
Escherichia coli strain CG1061 isolated from chicken cecum showed 93.7% and 61.8% degradation of AFB1, respectively. AFB1 was bio-transformed into AFD1 and other metabolites such as C
17H
12O
7, C
26H
25N
3O
12S, C
17H
15O
5, and C
8H
4O
3. AFD1 (C
16H
14O
5;
m/
z 287.09) is produced by the opening of the lactone ring of AFB1. Al-Owaisi et al. [
82], while studying the AFB1-detoxifying potential of herbal medicinal products, proposed a fragmentation pathway of AFB1 which showed the formation of product ions
m/
z 284 and
m/
z 258 due to two sequential losses of carbon monoxide, followed by the loss of the methoxy moiety (
m/
z 228), and a carbon monoxide and a formaldehyde moiety (
m/
z 188). The appearance of the product ions with
m/
z 206, 258, 284, and 287 following treatment of AFB1 with the culture supernatants of the rice weevil gut bacterial isolates in this study suggests degradation of AFB1.
The in vitro two-sealed base-plates assay in this study showed that
B. subtilis RWGB1,
B. oceanisediminis RWGB2, and
P. aeruginosa RWGB4 produced antifungal volatile compounds that suppressed the growth of
A. flavus. In contrast, the volatiles from
B. firmus RWGB3 were not effective against
A. flavus. The production of VOCs is recognized as an important mechanism by which antagonistic bacterial isolates suppress plant pathogenic fungi [
41,
42,
56,
83,
84,
85,
86]. These VOCs are gaseous, lipophilic, low-molecular-weight (<300 Da) compounds [
87] that disrupt fungal cell membranes, leading to the leakage of cell contents and, eventually, cell death [
88,
89]. Strobel et al. [
90] reported the synergistic antimicrobial activity of VOCs against plant pathogens.
Profiling of the VOCs produced by the rice weevil gut bacterial isolates in this study revealed that
B. subtilis RWBG1 primarily produced silane, trimethyl(1-methyl-1-propenyl)-, (E)-, silane, tetramethyl-, and pentamethyldisilane.
B. oceanisediminis RWGB2 predominantly produced butanoic acid, 2-methyl-, ethyl ester.
P. aeruginosa RWBG4 was found to produce 1-decanol as its major component. Antimicrobial activity of butanoic acid, 2-methyl-, ethyl ester (C
7H
14O
2; MW 130.1849; syn: Butyric acid, 2-methyl-, ethyl ester) has been reported [
90,
91]. Li et al. [
92] reported the antifungal effect of 1-decanol (C
10H
22O; MW 158.2811; syn: Decyl alcohol; Capric alcohol; Decanol) from antagonistic bacterium
Bacillus velezensis against
Verticillium dahliae and
Fusarium oxysporum. Gao et al. [
93] reported that the major VOCs produced by
B. subtilis strain CF-3 that showed antagonistic activity against
Monilinia fructicola and
Colletotrichum gloeosporioides were (
S)-1-octanol, benzoic acid, 2,4-di-
tert-butylphenol, benzaldehyde, and benzothiazole. However, in this study, silane, trimethyl(1-methyl-1-propenyl)-, (E)-, silane, tetramethyl-, and pentamethyldisilane were identified as major compounds produced by
B. subtilis RWBG1. Similarly, Al-Daghari et al. [
56] reported that an antagonistic strain of
P. aeruginosa B1-SQU obtained from cabbage rhizosphere, which showed inhibitory activity against
P. aphanidermatum, produced 1-Butanol, 3-methyl- (syn: Isopentanol/Isoamyl alcohol) and dimethyl disulfide as the major compounds. Al-Rashdi et al. [
86] showed that
P. aeruginosa PC5 obtained from
Prosopis cineraria produced dimethyl disulfide as the major VOC, followed by n-hexadecanoic acid and di-tert-butyl decarbonate, whereas 1-decanol was identified as the major component in this study. The variations in the chemical composition of these VOCs might be due to the difference in the type of culture medium, as well as the duration of incubation [
87]. In this study, silane, trimethyl(1-methyl-1-propenyl)-, (E)-, silane, tetramethyl-, and pentamethyldisilane were found as major components in both
B. subtilis RWBG1 and the control. However, VOCs from
B. subtilis RWBG1 contained an antifungal compound, decane, 2,3,5,8-tetramethyl-(C
14H
30; MW 198.3880; syn: 2,3,5,8-Tetramethyl-decane) in addition to the above compounds. Sholkamy et al. [
94] reported that volatile metabolites from
Streptomyces sp. nkm1 inhibited the growth of plant pathogenic fungi, including
A. flavus, and the bioactive fraction contained decane, 2,3,5,8-tetramethyl- as one of its components.